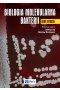
Biologia molekularna bakterii

Ebooki

Kartografia
Zasady i zastosowania geowizualizacji
Autorzy:
Beata Medyńska-Gulij
Data premiery: 12.10.2015
Format: 165 mm x 235 mm
Oprawa: miękka
Ilość stron: 260

Autorzy:
Jerzy Szwejda
Data premiery: 10.10.2015
Format: 165 mm x 235 mm
Oprawa: miękka
Ilość stron: 248

Autorzy:
Anna Sankowska
Data premiery: 24.09.2015
Format: 165 mm x 235 mm
Oprawa: miękka
Ilość stron: 120

Autorzy:
Thakaa Al-Khafaji
, Henryk Zobel
Data premiery: 15.09.2015
Format: 165 mm x 235 mm
Oprawa: twarda
Ilość stron: 320

Sagi islandzkie
Zarys dziejów literatury staronordyckiej
Data premiery: 14.09.2015
Format: 145 mm x 205 mm
Oprawa: miękka
Ilość stron: 208

Autorzy:
Alicja Żarowska-Mazur
Data premiery: 11.09.2015
Format: 168 mm x 205 mm
Oprawa: miękka
Ilość stron: 250

Autorzy:
Agnieszka Gmitrowicz
Data premiery: 09.09.2015
Format: 165 mm x 235 mm
Oprawa: miękka
Ilość stron: 273

Mit pieniądza
Świat realny wobec iluzji polityki pieniężnej
Autorzy:
Andrzej Sopoćko
Data premiery: 07.09.2015
Format: 165 mm x 235 mm
Oprawa: zintegrowana
Ilość stron: 270

Autorzy:
Witold M. Orłowski
Data premiery: 07.09.2015
Format: 145 mm x 205 mm
Oprawa: miękka
Ilość stron: 49

Hydraulika siłowa
Zbiór zadań z rozwiązaniami
Autorzy:
Piotr Sobczyk
Data premiery: 04.09.2015
Format: 165 mm x 235 mm
Oprawa: miękka
Ilość stron: 200

Data premiery: 01.09.2015
Format: 165 mm x 235 mm
Oprawa: miękka
Ilość stron: 308

Autorzy:
Marek Ludwicki
, Michał Ludwicki
Data premiery: 01.09.2015
Format: 165 mm x 235 mm
Oprawa: miękka
Ilość stron: 360

Autorzy:
Kazimierz Zieliński
Data premiery: 01.09.2015
Format: 165 mm x 235 mm
Oprawa: miękka
Ilość stron: 180

Autorzy:
Ryszard Aleksandrowicz
, Bogdan Ciszek
Data premiery: 28.08.2015
Format: 165 mm x 235 mm
Oprawa: miękka
Ilość stron: 212

Data premiery: 26.08.2015
Format: 205 mm x 285 mm
Oprawa: twarda
Ilość stron: 195

Autorzy:
Maciej Gibiński
, Wanda Konty-Gibińska
Data premiery: 26.08.2015
Format: 165 mm x 235 mm
Oprawa: miękka
Ilość stron: 128
Data premiery: 25.08.2015
Format: 205 mm x 295 mm
Oprawa: miękka
Ilość stron: 544

Autorzy:
Kathryn Asbury
, Robert Plomin
Data premiery: 18.08.2015
Format: 145 mm x 205 mm
Oprawa: miękka
Ilość stron: 196

Autorzy:
Kazimierz Czarnecki
Data premiery: 11.08.2015
Format: 160 mm x 235 mm
Oprawa: miękka
Ilość stron: 496

Leczenie osobistą pompą insulinową
Podręcznik dla pielęgniarek i położnych
Autorzy:
Teresa Benbenek-Klupa
Data premiery: 03.07.2015
Format: 165 mm x 235 mm
Oprawa: miękka
Ilość stron: 180

Autorzy:
Kazimierz Janicki
Data premiery: 30.06.2015
Format: 82 mm x 104 mm
Oprawa: miękka
Ilość stron: 424

Autorzy:
Richard J. Crisp
, Rhiannon N. Turner
Data premiery: 23.06.2015
Format: 165 mm x 235 mm
Oprawa: miękka
Ilość stron: 384

Autorzy:
Iryna Kononenko
, Irena Mytnik
, Elżbieta Wasiak
Data premiery: 12.06.2015
Format: 145 mm x 205 mm
Oprawa: miękka
Ilość stron: 550

ALFAbet motywacji.
Powiedz TAK swoim możliwościom budząc uśpione talenty
Autorzy:
Artur Wikiera
Data premiery: 29.05.2015
Format: 141 mm x 218 mm
Oprawa: miękka
Ilość stron: 200